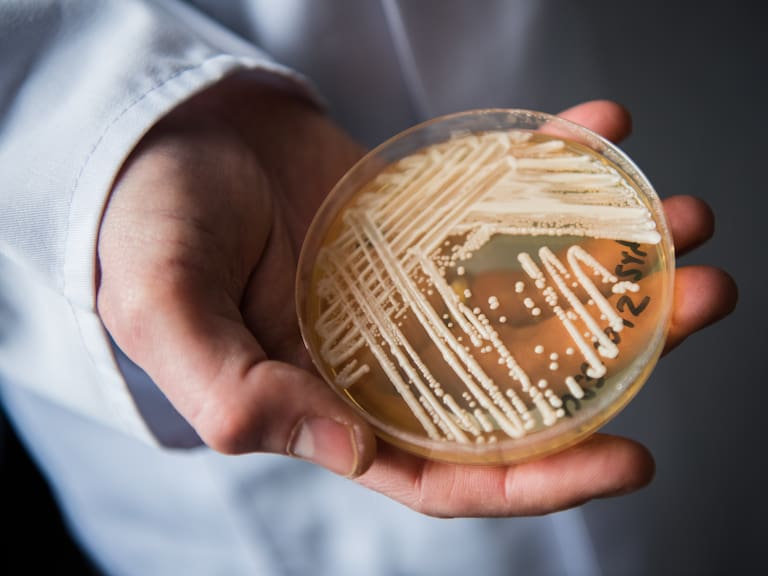
Candida Auris.

La trágica batalla de Javier Acosta: Candida auris, el hongo que desafía a la medicina
Un caso conmovedor que revela la letalidad y resistencia de un hongo que amenaza la salud global
Candida Auris. / picture alliance
Javier Acosta, un joven colombiano de 36 años, decidió someterse a la eutanasia después de una larga y dolorosa lucha contra una infección causada por el hongo, Candida auris. Su caso ha generado gran conmoción y ha puesto en el centro de atención los peligros de esta afección, que es especialmente difícil de tratar debido a su resistencia a la mayoría de los antifúngicos disponibles.
El inicio de la tragedia de Acosta se remonta a unas vacaciones familiares en la localidad de Melgar, al suroeste de Bogotá, donde contrajo la infección tras nadar en una piscina recreativa. Lo que comenzó como una aparente infección cutánea, progresó rápidamente hasta afectar gravemente su salud.
Con el tiempo, la infección derivó en osteomielitis, una peligrosa inflamación ósea, y eventualmente en un cáncer en la sangre, lo que deterioró aún más su estado físico.
Tras cinco años de dolor y sin esperanzas de recuperación, Acosta solicitó la eutanasia, una decisión que fue aprobada por un tribunal médico y se llevó a cabo el 30 de agosto.
Te puede interesar:
¿Cuáles son los síntomas que provoca este hongo?
Estos son los más comúnes:
- Fiebre persistente
- Escalofríos y sudoración
- Problemas en la piel
¿Por qué es tan letal?
Candida auris es extremadamente peligroso por varias razones:
- Resistencia a antifúngicos: Este hongo es resistente a muchos de los medicamentos antifúngicos disponibles, lo que hace que las infecciones sean muy difíciles de tratar. En algunos casos, puede mostrar resistencia a múltiples tipos de antifúngicos, complicando aún más el tratamiento.
- Diagnóstico complicado: Sus síntomas son similares a los de otras infecciones, lo que puede retrasar su diagnóstico. Detectarlo requiere pruebas de laboratorio específicas, y cualquier retraso en la identificación puede permitir que la infección se agrave.
- Alta mortalidad: Cuando infecta el torrente sanguíneo, órganos o sistema nervioso, la infección por Candida auris puede ser potencialmente mortal, especialmente en pacientes con sistemas inmunológicos debilitados.
La dificultad para diagnosticarlo y tratarlo a tiempo, junto con su capacidad para propagarse en entornos vulnerables, subraya la necesidad de mayor vigilancia y protocolos de prevención más estrictos, especialmente en hospitales y lugares con personas inmunocomprometidas.



